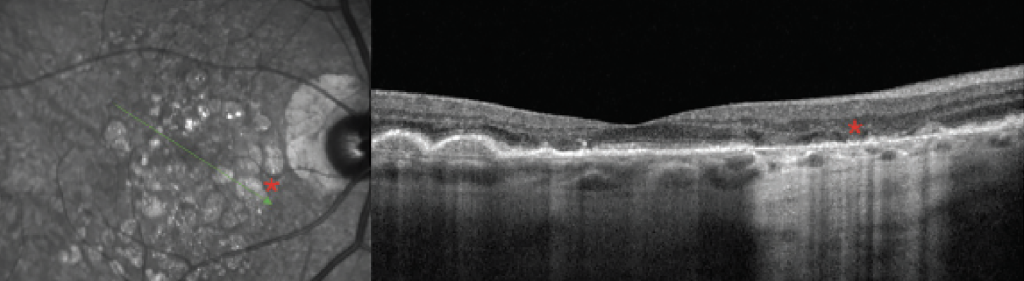

Este artículo y la imagen, fueron publicados y traducidos bajo los términos de nuestra licencia con Jobson Healthcare Information. Queda estrictamente prohibida su reproducción total o parcial.
Muchos dispositivos oftálmicos capturan múltiples tipos de imágenes, pero comprender los matices de cada uno aumentará su capacidad para detectar hallazgos sutiles.
 Por Rachel Steele, OD1
Por Rachel Steele, OD1
1 La Dra. Steele obtuvo su título de Doctora en Optometría en el Southern College of Optometry y completó su residencia en enfermedades oculares en el Centro Médico de Asuntos de Veteranos de Memphis, su especialización en optometría en enfermedades vítreorretinianas en el Charles Retina Institute en Germantown, Tennessee y actualmente es asociada del Charles Retina Institute y profesora consultora del Southern College of Optometry. Además, es diplomada de la Junta Americana de Optometría y miembro de la Academia Americana de Optometría.
Desde la publicación de las primeras imágenes del fondo de ojo en la década de 1880, los profesionales de la salud visual han presenciado avances extraordinarios en la fotografía del fondo de ojo. En el panorama actual de la imagen oftálmica, tenemos acceso a una gran variedad de modalidades de imagen para facilitar el diagnóstico y la documentación de las enfermedades del segmento posterior. Entre ellas se encuentran las fotografías a color, las imágenes pseudocolor, las imágenes de campo amplio y ultraamplio, la autofluorescencia del fondo de ojo (FAF) y las imágenes infrarrojas. Muchos dispositivos modernos pueden capturar múltiples tipos de imágenes; sin embargo, puede resultar difícil para los profesionales distinguir los matices entre estas imágenes. Apreciar la sutil diferencia entre estas modalidades de imagen puede ser enriquecedor si desea profundizar su conocimiento sobre los dispositivos de imagen y la patología retiniana.
Fotocromía
A pesar de ser uno de los primeros métodos de obtención de imágenes fundoscópicas, la fotografía a color tradicional sigue teniendo una relevancia significativa en la práctica y la investigación optométricas modernas. Las cámaras de color para el fondo de ojo iluminan una amplia zona del fondo de ojo con luz blanca y capturan la luz reflejada mediante una película o un sensor digital. Dado que estos dispositivos utilizan luz blanca, la imagen proporciona una representación fiel del color del fondo de ojo, similar a la oftalmoscopia, que los modernos oftalmoscopios láser de barrido (SLO) y las cámaras de campo amplio han intentado replicar.
Sin embargo, la fotografía de fondo de ojo a color presenta importantes inconvenientes, como un flash intenso que dificulta la adquisición para los pacientes, un campo de visión limitado y posibles artefactos de imagen. Las cámaras de fondo de ojo tradicionales capturan toda la luz reflejada, lo que permite la interferencia de opacidades lenticulares y luz dispersa fuera del plano focal, produciendo una imagen descolorida. 1,2 No obstante, la fotografía a color aún puede proporcionar imágenes detalladas y de alta calidad para documentar la patología retiniana y se sigue utilizando ampliamente en la práctica diaria y en ensayos clínicos.
SLO
La llegada del SLO revolucionó la imagenología del fondo de ojo al reducir la cantidad de luz necesaria para producir imágenes de alta calidad, ampliar el campo de visión y crear imágenes monocromáticas. En lugar de iluminar una zona extensa, estos dispositivos iluminan el fondo de ojo mediante un ráster horizontal de luz que lo escanea con una sola longitud de onda o con un pequeño ancho de banda. 3 Dado que estos dispositivos iluminan solo una pequeña porción del fondo de ojo a la vez, la retrodispersión de luz es mínima y la adquisición resulta más cómoda para los pacientes. Los dispositivos SLO tienen numerosas aplicaciones útiles, como la fotografía del fondo de ojo, la angiografía con colorante, la FAF, las imágenes sin rojo ni verde y las imágenes infrarrojas.

Muchos dispositivos de imágenes SLO modernos utilizan óptica confocal (cSLO), que restringe toda la luz fuera del plano de enfoque, creando una imagen con una resolución aún mayor y menos artefactos de las estructuras anteriores al fondo del ojo. 4 La OCT de dominio espectral (SD-OCT) a menudo utiliza óptica SLO para adquirir imágenes infrarrojas o sin rojo de alta calidad del fondo del ojo junto con el B-scan de OCT, incluso a través de una pupila pequeña.
Los dispositivos SLO modificados, como la cámara Optos, iluminan el fondo de ojo con longitudes de onda rojas y verdes, que se combinan para producir una imagen pseudocolor, que a menudo presenta un tono verdoso. Al examinar estas imágenes, es importante tener en cuenta que no son de color real, lo que puede alterar la interpretación de patologías como lesiones retinianas y coroideas. Optos California, un dispositivo SLO modificado de campo ultra amplio, incorpora un canal azul que permite el mapeo de la retina superficial y crea una imagen de color más real ( Figura 1 ).
Las imágenes monocromáticas con canales rojo, verde y azul crean esencialmente una vista segmentada de la retina, ya que cada longitud de onda penetra a una profundidad diferente en el tejido. El canal azul penetra la retina superficial y es útil para identificar defectos en la capa de fibras nerviosas retinianas o las membranas epirretinianas. El canal verde es útil para mapear las capas medias de la retina y el canal rojo es útil para estructuras más profundas como la retina externa, el epitelio pigmentario retiniano (EPR) y la coroides. 5 La alternancia entre estos canales de color puede ayudar a los médicos a segmentar artificialmente los niveles de la retina al evaluar diversas patologías.

Un buen ejemplo de esto es la distinción entre lesiones como la hipertrofia congénita del epitelio pigmentario de la retina (HPPR) y los nevos coroideos. Estos últimos desaparecen con filtros antivaho porque la luz verde es bloqueada por el HPPR y no penetra en la coroides. El HPPR permanece visible con un filtro antivaho porque se encuentra en el HPPR ( Figura 2 ). Ambas lesiones pueden permanecer visibles con filtros antivaho porque la luz roja penetra a través del HPPR donde se encuentra el HPPR, haciéndolo visible, mientras que el nevo es visible porque se localiza dentro de la coroides.
FAF
Esta es una herramienta de imagen poderosa y no invasiva que demuestra la salud metabólica de la retina y el EPR. 6,7 La FAF se basa en la presencia (o ausencia) de fluoróforos endógenos: estas son moléculas que absorben la luz en un cierto rango de longitudes de onda (espectros de excitación) y emiten luz desde longitudes de onda más largas (espectros de emisión). La angiografía intravenosa basada en colorante demuestra este concepto utilizando fluoróforos exógenos (fluoresceína sódica o verde de indocianina). La excitación de la fluoresceína sódica ocurre en las longitudes de onda azules y emite fuertemente en las longitudes de onda verdes. Después de la inyección de fluoresceína sódica intravenosa, el fondo del ojo se expone generalmente a una sola longitud de onda de luz azul mientras que el instrumento detecta un rango de longitudes de onda verdes, que aparecen como señales hiperfluorescentes en las imágenes. Si bien la FAF y la angiografía basada en colorante utilizan los conceptos de fluorescencia, son dos estrategias de imagen únicas y brindan información diferente.
La FAF fue descrita por primera vez por Delori et al., quienes observaron fluorescencia de 500 nm a 750 nm a partir de fluoróforos endógenos utilizando un “novedoso espectrofotómetro de fondo de ojo”. 8 En comparación con la angiografía intravenosa con colorante, la intensidad de la autofluorescencia es dos órdenes de magnitud menor que el fondo de una angiografía, lo que requiere una sensibilidad mucho mayor que la angiografía tradicional. 6,8 El principal fluoróforo endógeno visualizado con FAF es la lipofuscina. Esta sustancia está compuesta por aproximadamente 20 compuestos bisretinoides de N-retinilideno-N-retiniletanolamina. Se presenta como un subproducto metabólico en el ciclo visual y se acumula característicamente en una gran variedad de procesos patológicos, incluyendo la degeneración macular relacionada con la edad (DMAE) y los trastornos hereditarios de la retina. 6,7 La lipofuscina se absorbe fuertemente en el rango azul y tiene un pico de emisión entre 590 nm y 620 nm. 6
La FAF en un sujeto sano demuestra una señal de hiper-AF uniforme que se oscurece en la fóvea y la parafóvea debido a una alta concentración de pigmentos maculares (luteína y zeaxantina) y una mayor densidad de melanina, lo que reduce la señal de la autofluorescencia del EPR que se encuentra debajo. 6 El nervio óptico parece hipo-AF porque carece de fluoróforos, mientras que los vasos sanguíneos parecen hipo-AF debido a la absorción de luz por la hemoglobina dentro del vaso.

El aumento de la autofluorescencia indica disfunción metabólica de la retina externa y el EPR. La acumulación excesiva de lipofuscina resulta de procesos degenerativos como la DMAE o enfermedades retinianas hereditarias y conduce a hiper-FA. Otras causas de la señal de hiper-FA incluyen el líquido subretiniano crónico, que altera la fagocitosis de los restos del segmento externo, que se produce en afecciones como la coriorretinopatía serosa central o el desprendimiento de retina crónico. 6 La distribución anormal de los pigmentos maculares, que suelen estar altamente concentrados en la fóvea y la parafóvea, también puede conducir a hiper-FA. La telangiectasia macular tipo 2 ilustra bien este concepto: una característica de imagen distintiva temprana en esta afección es la hiper-FA sutil en la perifovea temporal debido al agotamiento del pigmento macular y la atrofia de los fotorreceptores ( Figura 3 ). La pérdida de estos pigmentos conduce a una mayor visibilidad de la autofluorescencia natural del EPR debajo.
Mientras que la hiper-FA suele indicar un aumento de lipofuscina en las células del epitelio pigmentario de la retina (EPR), la hipo-FA indica atrofia o ausencia de células del EPR. La atrofia del EPR puede ser consecuencia de diversas enfermedades degenerativas de la retina, como trastornos retinianos hereditarios, maculopatías tóxicas como la maculopatía por hidroxicloroquina, atrofia geográfica (AG) en la DMAE o tras un traumatismo o la fotocoagulación con láser. La cabeza del nervio óptico presenta hipoautofluorescencia debido a la ausencia total de fluoróforos, salvo por las drusas del disco óptico en la hiper-FA. El bloqueo de la señal por artefactos o hemorragias retinianas también provoca una disminución de la autofluorescencia.

La autofluorescencia azul (FAF) se realiza comúnmente con dispositivos cSLO o dispositivos de imagen de campo ultra amplio adaptados, ampliamente accesibles en la práctica clínica (Spectralis HRA, Heidelberg; Optos). Estos dispositivos suelen utilizar autofluorescencia azul (BAF), que expone el fondo de ojo a luz azul (~488 nm) y detecta la emisión en el rango de 500 nm a 700 nm. 6 El pigmento macular absorbe fuertemente a esta longitud de onda, creando una señal de hipo-AF en la fóvea. La autofluorescencia verde (GAF) es una incorporación relativamente más reciente que expone el fondo de ojo a luz verde (~514 nm o 532 nm), que está fuera de las longitudes de onda de máxima absorción del pigmento macular y tiene menos interferencia de opacidades lenticulares ( Figura 4 ). En publicaciones recientes, se sugiere que la GAF es superior para medir lesiones de AG foveales porque hay menos interferencia del pigmento macular suprayacente que puede oscurecer los bordes de la lesión. 9

Existen innumerables aplicaciones de la FAF en la práctica clínica, siendo la más práctica detectar o monitorear la progresión de la AG en pacientes con DMAE. El Informe 3 de la Reunión sobre Clasificación de Atrofia (CAM) describió los hallazgos de la FAF en la AG como (1) bordes claramente demarcados, (2) una señal de hipo-AF similar a la cabeza del nervio óptico o los vasos sanguíneos de la retina, y (3) un diámetro de ≥250 µm. 10 La detección temprana de la AG es importante para la educación del paciente sobre su estado de enfermedad, así como para una posible intervención terapéutica. Alternativamente, la FAF se recomendó en las pautas de la Academia Estadounidense de Oftalmología de 2016 para la detección de la maculopatía por hidroxicloroquina y se recomienda anualmente además de la OCT y la prueba del campo visual 10-2 después de cinco años de uso del fármaco. 11 La FAF de campo ultra amplio también es una herramienta poderosa para detectar la enfermedad retiniana hereditaria o la enfermedad uveítica, las cuales a menudo tienen hallazgos tempranos sutiles en el examen clínico ( Figura 5 ).
Infrarrojo
Este formato de imagen es una modalidad poco conocida y poco utilizada, con una alta sensibilidad para mostrar cambios estructurales en la retina externa, el epitelio pigmentario retroperitoneal (EPR) y la coroides. Piccolino et al. fueron los primeros en observar el patrón autofluorescente del fondo de ojo al iluminarlo con luz infrarroja mientras investigaban la pseudofluorescencia en la angiografía con verde de indocianina. 12 En aquel momento, sospecharon que el sutil patrón autofluorescente representaba la distribución de melanina, sangre y lipofuscina en el fondo de ojo. 12
Nuestra comprensión de las imágenes de fondo de ojo en el infrarrojo cercano (nIR) ha mejorado significativamente desde entonces. A diferencia de la autofluorescencia de onda corta (BAF, GAF), la imagen infrarroja utiliza longitudes de onda largas que penetran más profundamente en la retina y la coroides y no son absorbidas por el pigmento macular. Las longitudes de onda infrarrojas que entran en el ojo se absorben, reflejan o dispersan.<sup> 13</sup> La absorción de las longitudes de onda infrarrojas es significativamente menor que la de la AF de longitud de onda corta, lo que significa que se refleja más luz y se necesita menos para adquirir las imágenes. Los sistemas confocales SLO se utilizan en la imagen infrarroja actual, que restringen gran parte de la luz reflejada fuera del plano focal del dispositivo, creando una imagen de alta calidad. Los principales absorbentes de luz infrarroja en el fondo de ojo son la melanina, el agua y la sangre, que oscurecen los vasos sanguíneos y el disco óptico.<sup> 13</sup> Las imágenes infrarrojas se adquieren fácilmente junto con la SD-OCT y ofrecen importantes ventajas frente a alternativas como las imágenes sin rojo, como la capacidad de penetrar fácilmente en pupilas pequeñas y la comodidad para los pacientes durante la adquisición. No se necesita flash para obtener imágenes, y las longitudes de onda infrarrojas quedan fuera del espectro visible.
Las imágenes infrarrojas son un recurso valioso que puede ayudar a interpretar otras modalidades de imagen como OCT y FAF y a menudo pueden detectar enfermedad macular sutil como drusas tempranas o depósitos drusenoides subretinianos (anteriormente pseudodrusas reticulares), que pueden ser visibles en imágenes infrarrojas pero no clínicamente evidentes. Los informes de CAM también destacaron el uso de imágenes infrarrojas en DMAE para detectar GA ( Figura 6 ). Los hallazgos infrarrojos de GA se definieron como lesiones altamente reflectantes mayores de 250 µm con bordes bien definidos. 10 Mientras que las lesiones de GA son hipo-FA con FA de longitud de onda corta, aparecen tan brillantemente reflectantes con nIR ya que las longitudes de onda infrarrojas son fuertemente reflejadas por la esclerótica. Las longitudes de onda infrarrojas también tienen uso para resaltar lesiones maculares inflamatorias como las que se observan en la neurorretinopatía macular aguda, que aparecen como lesiones petaloides oscuras correspondientes a áreas de interrupción de la zona elipsoide observadas en OCT, pero pueden no ser clínicamente evidentes ( Figura 7 ). Estas imágenes también son útiles para detectar complejos neovasculares sutiles en la retinopatía diabética proliferativa que son difíciles de visualizar clínicamente sin angiografía con fluoresceína.

Si bien las imágenes infrarrojas tienen una alta sensibilidad para la detección de enfermedades degenerativas de la retina y la mácula, también se han utilizado para el diagnóstico de diversas afecciones sistémicas, como la neurofibromatosis tipo 1 (NF1). La NF1, una afección autosómica de herencia dominante, conduce a la proliferación de células de la cresta neural, lo que causa la formación de varios hamartomas y tumores. 14 Algunos hallazgos característicos de la NF1 son manchas café con leche, pecas inguinales, nódulos de Lisch en el iris y, recientemente, anomalías coroideas irregulares brillantes visibles con imágenes nIR del fondo de ojo ( Figura 8 ). Histológicamente, estas áreas eran grupos de melanocitos y se denominaron hamartomas melanocíticos. Estas anomalías coroideas en la OCT infrarroja, junto con los nódulos de Lisch, forman parte del criterio diagnóstico revisado para la NF1, que se actualizó en 2021. 15 Se cree que estas lesiones son visibles con infrarrojos debido a su alta concentración de melanina, que parece brillante con luz infrarroja. 14

Las imágenes infrarrojas de alta calidad son una herramienta valiosa cuando se combinan con otras modalidades como la FAF y la OCT. Pequeñas anomalías pueden llamar la atención sobre hallazgos sutiles que podríamos pasar por alto con solo observar la OCT. Juntas, estas técnicas de imagen proporcionan una visión más completa de la salud de la retina.
Conclusiones
La imagenología del fondo de ojo se ha convertido en una herramienta indispensable en optometría, proporcionando información crucial sobre la estructura y función de la retina. Estas técnicas ofrecen ventajas únicas en el diagnóstico y monitoreo de una amplia gama de enfermedades de la retina y del nervio óptico. Si bien la fotografía a color del fondo de ojo sigue siendo un método fundamental para documentar la apariencia de la retina, las modalidades avanzadas mejoran la visualización de patologías sutiles y cambios metabólicos, a menudo antes de que sean clínicamente evidentes. En conjunto, estas tecnologías permiten una detección temprana, un diagnóstico más preciso y un mejor manejo de las afecciones de la retina. Familiarizarse con las particularidades de estos dispositivos de imagenología es el primer paso para incorporarlas a la atención de sus pacientes.
Bibliografía:
https://www.reviewofoptometry.com/article/the-fine-art-of-retinal-photography

